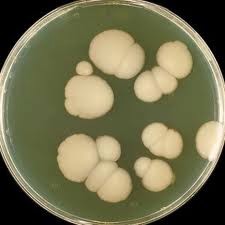
Кандидоз легких

Ложноастматические синдромы

Ложноастматическиие синдромы представляют собой особую группу заболеваний, которые сопровождаются удушьем, их симптомы очень схожи с симптомами бронхиальной астмы. Такие приступы могут возникать при аллергических заболеваниях, при отеке Квинке, анафилактическом шоке. Очень часто синдромы происходят на фоне приема лекарственных средств. Читать далее
Легочное сердце

Легочное сердце представляет собой состояние гипертрофии правого сердечного отдела, которое может возникнуть при неспецифических хронических болезней легких, тромбоэмболии, в основе заболевания легочного сердца лежит повышение давления крови в малом кругу. Различаются хроническое, подострое, острое течение.
Симптомами являются набухание шейных вен, увеличена печени, цианоз, отдышка, замедление СОЭ, увеличение гемоглобина, числа эритроцитов. Читать далее
Кровотечение легочное

Легочное кровотечение представляет собой излияние крови в просвет бронхов. Эта кровь (чистая ибо смешанная с мокротой) затем выделяется вместе с мокротой.
Причинами этого кровотечения могут стать: деструктивные формы заболеваний, туберкулезы гангрена абсцесс. Распадающийся рак легких. При туберкулезе кровотечения осложняют казеозную пневмонию, инфильтративные формы, фиброзные процессы. Читать далее
Кашель

Кашель – сильный выдох, который позволяет очистить верхние пути и легкие от мокроты либо инородных объектов. Вызывается кашель сокращением мышц, которое происходит при раздражении рецепторов. Также кашель часто возникает из-за стекания слизи по стенке горла.
Причиной появления кашля выступают инфекционные заболевания дыхательной системы, обструктивные болезни легких, повреждение легких (при курении), раздражение пищевода, горла. Читать далее
Кандидоз легких
Кандидоз легких вызывается поражениями грибами рода Candida, которые включают в себя более восьмидесяти видов, из них пятнадцать – патогенны для человека. Такая болезнь может развиваться при ослабленном иммунитете, при длительных сроках лечения при помощи антибиотиков, при лучевой терапии, химиотерапии.
Симптомами являются тахикардия, одышка, лихорадка, мучительный кашель, боли в груди, скудная мокрота, иногда с кровью. Читать далее
Интерстициальные заболевания легких
Интерстициальные заболевания представляют собой воспалительные процесса в соединительных тканях (кровеносных сосудах, альвеолах). При этом происходит сдавливание альвеол, они замещаются соединительной тканью, образуется фиброз.
Примерно половина подобных случаев имеет неизвестную природу, эти формы получили названия фиброзирующего альвеолита, синдрома Хаммана-Рича, легочного фиброза. Читать далее
Инородное тело трахеи и бронхов

Инородные тела трахеи, бронхов – это чужеродные тела, которые попали в полость этих органов. Обычно они попадают в просвет гортани, бронхи, трахею по неосторожности, в результате проглатывания маленькими детьми. Также это возможно при рвоте, наличии зубных протезов, при привычке постоянно держать во рту различные предметы. Читать далее
Инородное тело глотки

Инородное тело в глотке – это чужеродный предмет, который попал в ее полость. Обычно инородные тела попадают вместе с едой, это могут быть кости, кусочки дерева, шелуха, реже – булавки, зубные протезы, гвозди. Также большие куски пищи при плохом пережевывании либо спешном проглатывании могут перекрывать вход в гортань, вызывать удушье. Читать далее
Дыхательная недостаточность
Дыхательная недостаточность — специфическое патологическое состояние, которое напрямую связано неспособностью дыхательной системы обеспечивать дальнейший газообмен. Читать далее
Грибковые поражения

Грибковые поражения органов дыхательной системы носят название пневмомикозов, могут принимать разную форму. Вызываются грибками, могут стать вторичными поражениями на фоне хронических заболеваний, при ослаблении иммунитета, при методах лечения противоопухолевыми препаратами.
Некоторые формы (нокардиоз, гистоплазмоз) могут стать вторичными, проявиться у работников шахт, птицеферм, дорожных рабочих. Читать далее